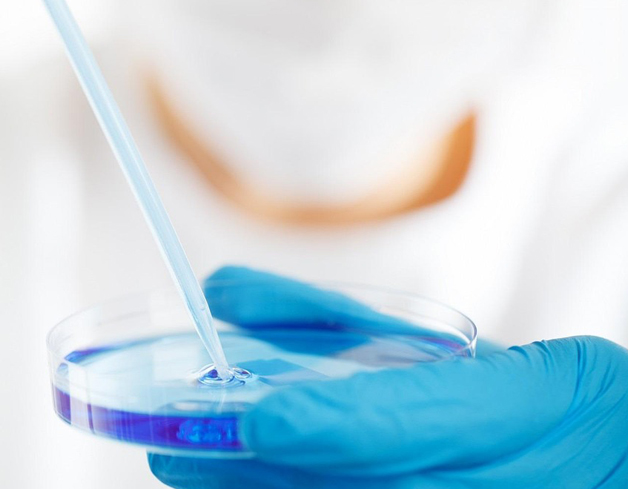
img

ZONE D’INTERVENTION
Une implantation stratégique en Afrique de l’Ouest
BE.PHARMA LABORATOIRE a choisi de construire sa présence régionale sur la base d’un déploiement réfléchi et maîtrisé. Notre ambition est de devenir un acteur clé de la représentation pharmaceutique en Afrique de l’Ouest, en assurant une couverture professionnelle, cohérente et durable dans les pays à fort potentiel.
Présence actuelle : Côte d’Ivoire